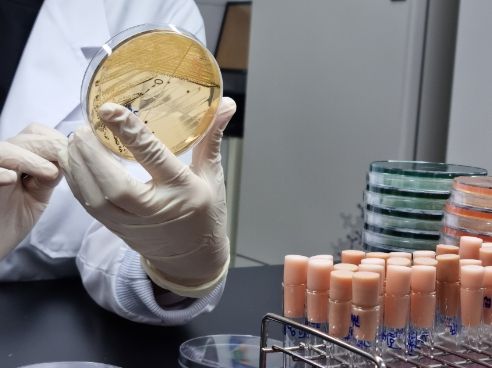

[ 중앙뉴스미디어 ] 광주광역시보건환경연구원은 일교차가 큰 가을철에 식중독 발생 우려가 있어 위생관리에 주의해 줄 것을 당부했다.
실제 광주지역 최근 5년간(2018~2022년) 식중독 발생 현황을 분석한 결과, 발생건수는 여름철(6~8월)이 36건 중 13건(36.1%)으로 가장 높았으나 환자 발생 수는 가을철(9~11월)이 총 270명 중 99명(36.7%)으로 여름철 91명(33.7%)보다 다소 높은 것으로 나타났다.
이는 일교차가 큰 가을철은 낮 기온이 높아 식중독균이 잘 증식되고, 조리된 음식을 장시간 상온에 보관할 경우 식중독 발생 우려가 크기 때문이다.
가을철 식중독은 주로 세균성 병원체가 원인이며, 최근 광산구 배달 도시락으로 인한 대규모 식중독도 살모넬라균이 원인병원체로 밝혀졌다.
광주보건환경연구원이 광주지역 12개 의료기관과 연계해 매주 실시하고 있는 수인성·식품매개 감염병 감시사업 분석 결과, 9월부터 최근 5주간 검출된 병원체는 전체 66건 중 병원성대장균 29건(43.9%), 살모넬라균 15건(22.7%) 등 식중독균이 67%를 차지했다.
병원성대장균에 의한 식중독의 주요 원인은 오염된 채소류와 생고기, 완전히 조리되지 않은 식품이다. 살모넬라균은 오염된 달걀, 우유, 육류 및 가공품이 주요 감염원으로 음식물이나 조리환경 관리에 잠시만 소홀해도 주위 환경을 쉽게 오염시킬 수 있어 철저한 위생관리가 요구된다.
광주보건환경연구원은 식중독 발생 시 신속한 원인규명 및 확산방지를 위해 비상근무체계를 운영하고 있으므로 식중독이 의심될 경우 보건소에 즉시 신고해줄 것을 당부했다.
강경리 수인성질환과장은 “식품이 식중독균에 오염돼도 냄새나 맛의 변화가 거의 없어 육안으로는 음식이 상했는지 판별할 수가 없으므로 음식물 취급과 보관에 주의를 기울여야 한다”며 “온도가 높은 차량 내부, 트렁크 등에 조리식품을 2시간 이상 방치하면 식중독균 증식의 위험이 있으므로 아이스박스에 아이스팩을 넣어 신선하게 운반하는 것이 좋다”고 당부했다.
[뉴스출처 : 광주광역시]










